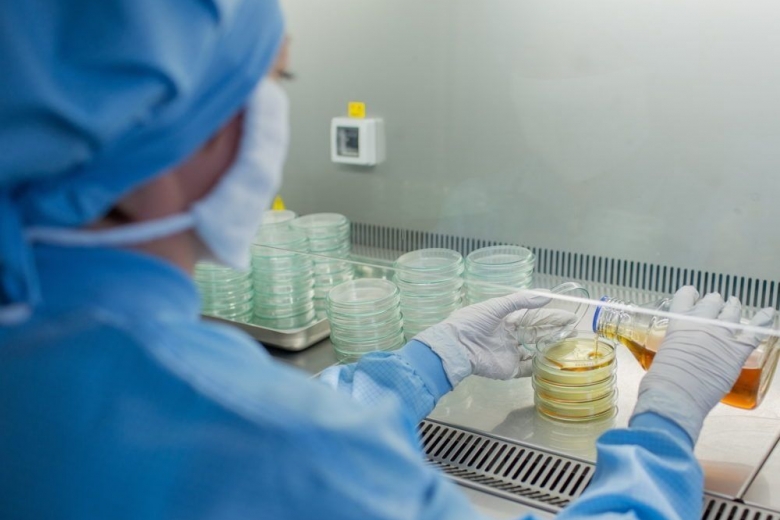

Клинические испытания украинского лекарства для борьбы с коронавирусом Биовен происходят с согласия пациента, сообщила сегодня замминистра здравоохранения Ирина Микичак.
"Биовен – это препарат украинского производителя, который показал свою успешность при ряде заболеваний. Минздрав в соответствии с действующими приказами министерства утвердил предложение Государственного экспертного центра (ГЭЦ).
РАСКРЫТА ЗАГАДКА ПОВТОРНОГО ЗАРАЖЕНИЯ COVID-19
Для того, чтобы принять решение о клинисследованиях, производитель обращается в ГЭЦ с пакетом документов, определяет медучреждения, где проводятся испытания. В пакет документов входит соглашение медучреждения и обязательное решение комиссии по этике в этом медучреждении. Испытания проводятся по согласованию пациента, больше того пациент страхуется. Выбор медучреждений и сам процесс исследований соответствуют порядку проведения клинических испытаний",- рассказала она.
Она отметила, что лекарственное средство Биовен является препаратом украинского производителя. По ее словам, он уже показал свою эффективность при целом ряде сложных хронических заболеваний.
Подпишись на наш ТЕЛЕГРАММ- КАНАЛ - узнай, чем так опасен икоронавирус